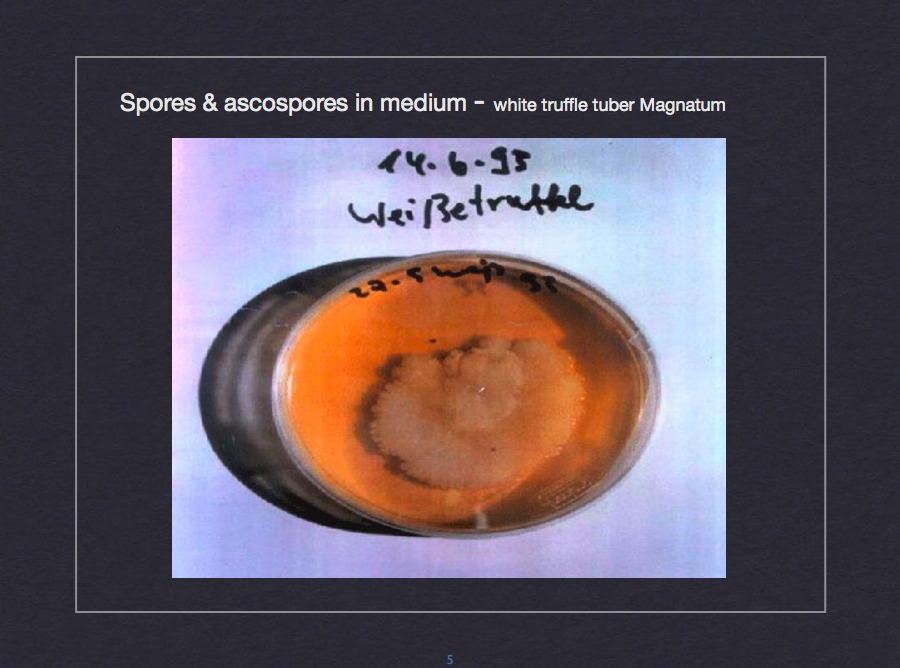
Spores and ascospores in medium - white truffle Tuber Magnatum

Welcome to Institute Dr.Khanaqa
Professional truffle cultivation research and truffle-infected seedlings production
Service Areas
Germany, France, Greece, Bulgaria, Cyprus, Iraq and Saudi Arabia
Cultivation of Truffles
Truffles - Diamonds for Gourmets
Since time immemorial, this most precious of all edible mushrooms has exhibited a mystical aura. The mystery of its formation seemed impossible to solve. Just where in the ground these desirable mushrooms developed was always left to chance. And so these unique treasures of nature could be reaped only after laborious searching and with great fortune. Although highly valued by gourmets, truffles remained a well-protected secret of nature.
Truffles - Cultivation Opens Up New Perspectives
After intensive research work over about twenty years, it is now possible for the first time ever to produce the most precious of all mushrooms in a systematic way. The agronomist and microbiologist Dr.Khanaqa pursued this aim with commitment and scientific accuracy for many years. He succeeded in developing a new procedure that makes it possible to cultivate truffles on a large scale.
Truffles - Infection Leads to High Yields
Truffles are the fruit bodies of a subterranean mushroom. They develop only in symbiosis with the root system of certain hardwood trees. Under ideal conditions in nature, the roots of these trees are infected by fungal spores and a truffle starts to grow. The procedure developed by Dr.Khanaqa emulates this process with painstaking care. The seedlings of selected trees - especially oaks and hazelnuts - are infected by hand with truffle spores produced and multiplied in vitro. The initial material for these infections are truffles themselves, obtained from the best Italian and French truffle-producing regions and competently imported.
Truffles - The Oak's Strength Guarantees a Rich Harvest
The purposeful cultivation of truffles is only possible by this infection process. The hand selected oak and hazelnut seedlings originate exclusively from traditional truffle regions and are raised under stringent control in the Dr.Khanaqa Research Institute. At an age of least eight months the truffle infected seedlings are sold for planting on your own field areas. An infection rate of almost one hundred percent is guaranteed by the Institute.
Truffles - High Yields in Only a Few Years
First yields of about 35 - 100 grams of truffles per seedling will be obtained only three years after planting. With an average lifetime of about 30 years, the plantation's yield increases year by year under optimal conditions. Besides the small annual costs for maintenance, the only investment you have to make is to purchase the truffle-infected seedlings.
Truffles - Research Generates Great Rewards
The cultivated truffles differ neither in taste nor in quality from those growing wild. This has been confirmed by various experts and gourmets. Truffle cultivation according to the method of Dr.Khanaqa is a particularly lucrative cropping.
Research & Science
Dr.Khanaqa's Scientific Methodology and Research Findings

Note: All research and methodology presented here has been developed and validated by Dr.Khanaqa through extensive laboratory work and field trials across multiple locations.
Cultivation of Truffle-infected Plants According to the Method of Dr.Khanaqa
1. Site Selection
Climatic Requirements
| Mean daily temperature: |
Summer: 17.0°C to 40.0°C
Winter: -5.0°C to 8.0°C
|
| Annual rainfall: | 300 mm to 1500 mm |
| Time of rainfall: |
Brief, heavy rainfall in spring will trigger the initial truffle growth. Brief, heavy rainfall in summer or autumn will ensure high yields. |
| Periods of drought: | In case of long droughts (> 20 days), irrigation is essential. |
Soil Conditions
For the commercial cultivation of truffles, the field should be free draining, well aerated, sufficiently calcareous (pH value) and deficient in nitrogen. Loess soil is favoured for growing truffles, because it fulfils the required conditions. However, it is also possible to grow truffles on light, sandy soil or on chalky soil. Chalky soil can only be recommended in very special cases (and only for Périgord truffles).
pH Value
The pH value of the soil is one of the most important conditions for viable cultivation of truffles. Ideally, the natural pH value of the soil should range between 7.0 and 8.5. For a pH value below 4.5, truffle production will be inhibited because of aluminium toxicity. If the deviations are small, it is possible to regulate the pH value (raising the soil pH by liming).
Mineral and Nutrient Content of the Soil
- Macro elements: N, P, K, Mg
- Micro elements: B, Cu, Mn, Zn
- C/N ratio
The most favourable mineral composition for truffle production varies from soil to soil, since it depends on many different factors, such as soil type, soil structure and content of organic matter. Accordingly, it is not possible to specify generally valid conditions. Before establishing a "truffle", or truffle plantation, it is absolutely imperative that the soil in question be analyzed and evaluated for its suitability. Both the topsoil (15 - 30 cm) as well as the subsoil (30 - 60 cm) should be examined because they are very vital for the relationship between fungus and host (topsoil) and general root activity (subsoil). Soils with a high heavy-metal content are unsuitable for growing truffles, because the development of fruit bodies (i.e. truffle formation) will be delayed or even inhibited.
A truffle should not be established on an area which has been used intensively for normal agriculture, since these soils usually exhibit a high level of nutrients and frequently also pesticide residues.
2. Establishing a Truffle
Preparing the Ground
In order to aerate the soil and remove the weeds, the soil should be ploughed first (ploughing depth 30 cm).
Planting
| Planting time: | Autumn (October/November) or March. The truffle-infected plants are delivered in pots. The trees should be planted together with the entire substrate in the pot, as it is penetrated by the inoculated root system. |
| Planting density: | 1000 - 1200 plants/hectare |
| Planting distance: | 3 meters distance within and between the rows |
| Planting system: | Monoculture or mixed cultivation is possible. Alternate planting of the seedlings (hazel, oak, olive, almond) within the rows, as well as hexagonal close packing, is recommended. Mixed planting offers the benefit that the stronger vegetation of hazels will promote the development of fruit bodies, thereby ensuring earlier and better yields. However, the cultivation of hazelnut saplings involves more work, as the foliage has an acidifying effect on the soil and must therefor be transported out of the field in autumn. |
3. Maintenance and Cultivation Work
Irrigation
To guarantee proper growth of the truffle-infected trees, thorough moistening of the soil is imperative. In almost all cases, watering is needed during the first few months after planting. Furthermore, supplementary irrigation is advised from the first to the third year.
To ensure high yields, the field must be irrigated whenever necessary during the whole period of cultivation to increase the yield.
Irrigation quantity and frequency vary strongly, depending on the soil type and climatic conditions.
Irrigation systems:
- Overhead irrigation/sprinklers
- Mini-sprinklers
- Droplet irrigation (spiral irrigation pipes)
Quality of the irrigation water: The presence of pesticide residues must be excluded. Undesirably high nutrient or pollutant levels should be removed (with the aid of an osmosis installation, for example).
Soil Cultivation and Care
Rotary tillage: In the fourth and sixth month after planting, at a depth of 3 - 5 cm. In the following years, twice a year in the same manner. The aim in soil preparation is to aerate the soil and to remove the weeds during the cultivation period.
In autumn, the hazel foliage must be taken out of the plantation, because otherwise it would acidify the soil (i.e. reduce the pH value).
Whenever necessary, correction of the soil pH (liming) should be carried out.
Fertilization: Organic manuring, in order to raise the levels of organic matter in the plantation and to stabilize the soil moisture content. A mixture of vegetable and animal products should be added, with pH < 8.0 and carbon/nitrogen ratios about 10 or more.
Plant Protection
Damage caused by wild boars, hares, rabbits, mice or squirrels: The truffle should be fenced in. Fencing could also be necessary to prevent theft of the truffle-infected plants and the truffles themselves.
Parasites: Leaf-rolling caterpillars, aphids, truffle fly (Suilla gigantae, formerly Heliomyza tuberivora) in France and Italy.
Fungal diseases of the host plants: Powdery mildew, for example.
Lifetime of a Truffle
With long term production, the brules (truffle-producing zones, whereby the truffles tend to grow at the edges) grow and coalesce. It is then necessary to remove individual trees to increase the space between the remaining trees.
Almonds 20 - 25 years, hazels and olives about 25 - 30 years, oaks on average 30 years. Given suitable pruning and thinning out of the trees with increasing age, the truffles may produce for up to 50 years (oaks).
4. Harvest
Harvest Methods
- Dogs (specially trained)
- Pigs (used traditionally because of their natural sense of smell, but no longer)
- Mature truffles are indicated by cracks in the soil (but only light soil)
- Another pointer to ripe truffles is the appearance and "dance" of the truffle fly (France, Italy)
- Careful digging with a spade. Avoid injuring the root system!
- Electronic detectors, detection of the volatile substances emitted by the mature truffles (flavour, perfume)
Harvest Time
| Summer truffle (T.aestivum Vitt.) | Summer (June - July) |
| Khanaqa truffle (hybrid: T.melanosporum Vitt. x T.magnatum Pico) | Middle of March - middle of May |
| Perigord truffle (T.melanosporum Vitt.) | Winter (November - March) |
| Arabian truffle (Terfieza) | Spring |
Start of Production and Yields
About 3 years after planting:
| Summer truffle (Italy, France) | 150 - 450 g/oak |
| Khanaqa truffle | 150 - 450 g/oak |
About 3.5 years after planting:
| Perigord truffle (France) | 150 - 450 g/oak |
| Arabian truffle | 450 - 650 g/oak |
If the conditions for growing truffles (soil, climate) are favourable, the plantation's yield increases year by year.
Prices (2001)
| Summer Truffle | 200 - 300 US$/kg |
| Arabian Truffle | 130 - 150 US$/kg |
| Khanaqa Truffle | 800 - 1,000 US$/kg |
| Perigord Truffle | 1,500 - 2,000 US$/kg |
Crop Yields (2001)
| Italy and France in total | about 130,000 - 140,000 kg/year |
| Summer truffle (Italy, France) | about 110,000 kg/year |
| Périgord truffle (France) | about 25,000 kg/year |
Characteristics of the Truffle Types
| Summer Truffle: | Flavour weaker than the White and Perigord truffles, but earlier and higher yields, sold fresh and tinned |
| Khanaqa Truffle: | Hybridization of Perigord and White truffle, quality similar to these types, flavour weaker than the parental generation, but earlier and higher yields |
| Perigord Truffle: | Strong flavour, sold fresh, high price |
| Arabian Truffle: | Weaker flavour than the Perigord truffle |
Prices
Please contact us for current pricing on truffle-infected seedlings and consultation services.
Our team will be happy to provide you with detailed pricing information and answer any questions you may have about truffle cultivation.
Gallery
























Contact
Phone
003 - 5386-2272362
009 - 6477-01574989
Fax
004 - 9982-5030
003 - 5323-51854
 English
English
 Deutsch
Deutsch
 Français
Français
